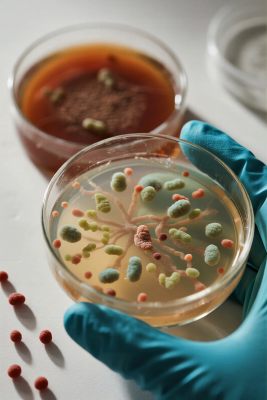
实验室微生物培养皿场景 实验室微生物培养皿场景
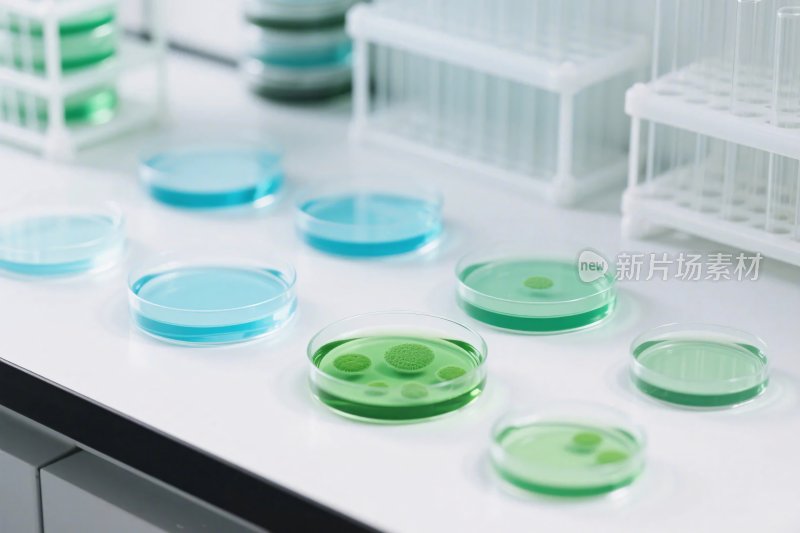
实验室培养皿场景
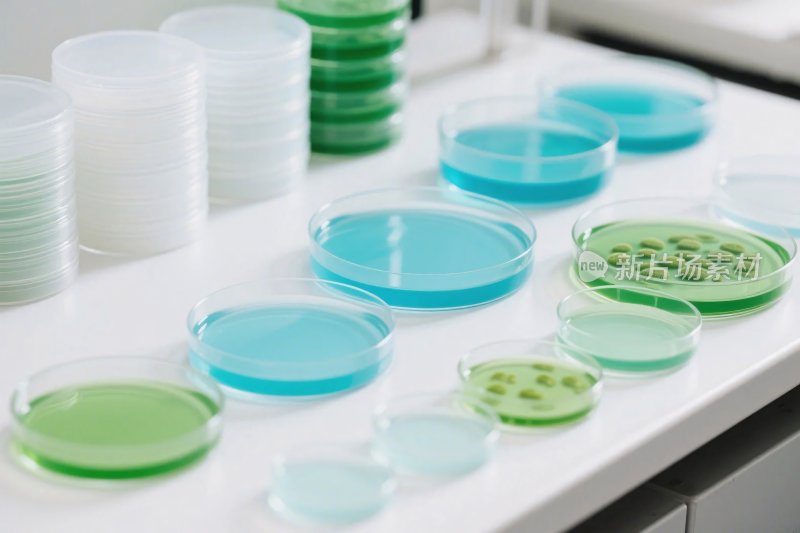
实验室培养皿与实验器具
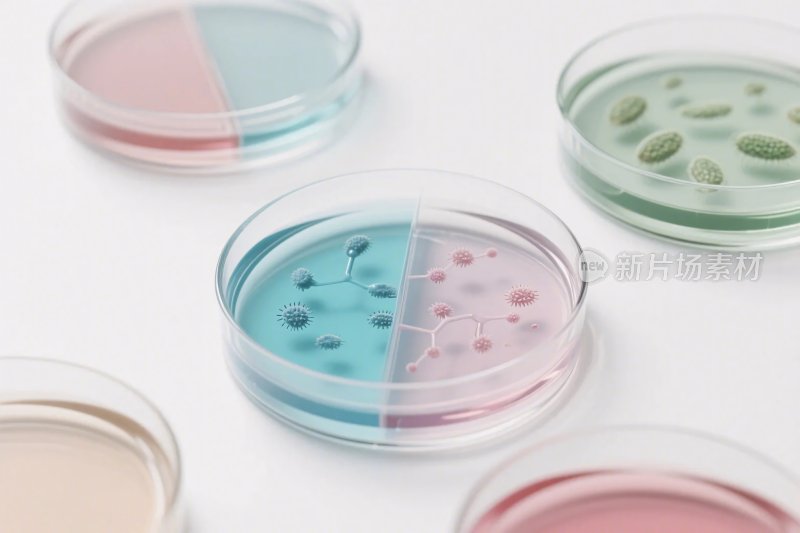
培养皿微生物插画
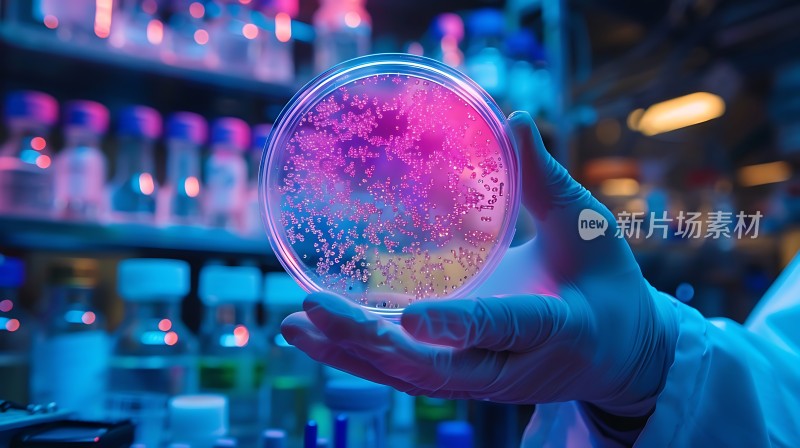
实验室中观察培养皿里的微生物样本
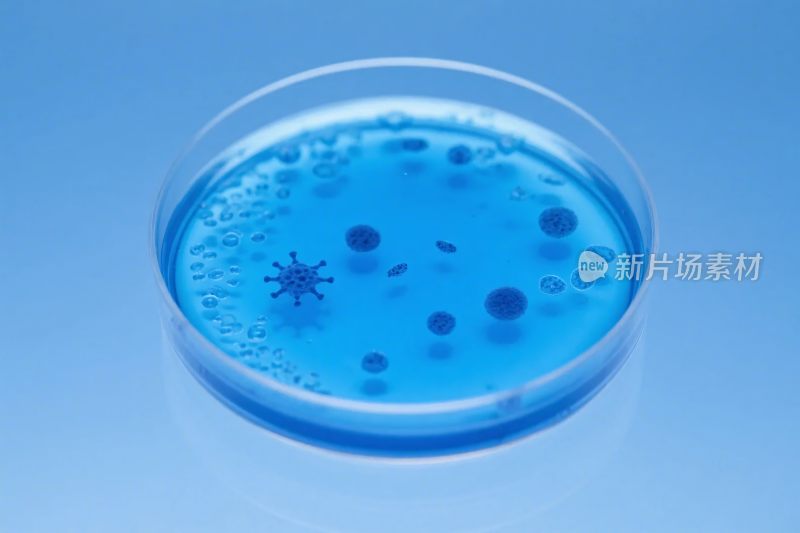
蓝色培养皿微生物示意图

素材详情
素材标题:
实验室微生物培养皿场景
素材ID:
FEUDV2mG1Hys7R4
是否包含AI生成内容:
是
字体:
仅供参考,无商业授权
更新时间:
2025-11-06 00:40
- 个人授权
企业标准授权
 折扣卡最低价78元 JPG¥ 130
折扣卡最低价78元 JPG¥ 1302.07 MB
加入购物车 立即购买
付费设计素材用途

网络传播用途
互联网广告、企业自媒体、短视频、直播、课程、app、游戏内应用等

线下展示用途
赛事、会议、仪式、演出、展会、经营场所播放等活动

线下印刷50万份
书籍、杂志、报纸、期刊,非转售类的宣传册、海报等印刷

渠道广告用途 请 联系客服 购买
电视、地铁、商场、电梯等渠道广告

转售品用途 请 联系客服 购买
印刷于艺术品、生活用品、服饰等实物商品,或主题皮肤、售卖课件等网络商品

影视传媒 请 联系客服 购买
电影、综艺、纪录片、电视剧等荧幕作品
 使用限制
使用限制供稿人上传作品中如含有的国旗国徽等党政图案仅作为整体效果示例展示,对于该类内容请创作人务必遵循法律法规的规定进行使用。